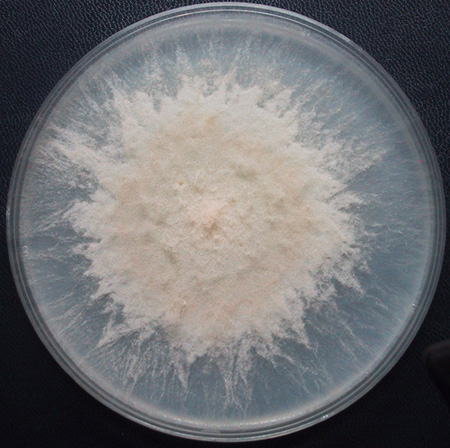

Grown 5 days on Vogels Minimal for 5 days at 25 C

Micrograph of hyphae grown between sheets of cellophane for 24 - 48 hrs at 25 C
Grown 5 days on Vogels Minimal for 5 days at 25 C |

Micrograph of hyphae grown between sheets of cellophane for 24 - 48 hrs at 25 C |